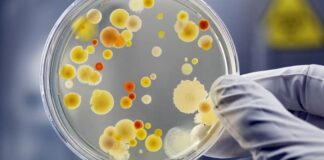
Microbios con «código de barras» para rastrear el origen de los alimentos

Etiqueta: Código de barras
Microbios con «código de barras» para rastrear el origen de los...
Madrid- La trazabilidad de los productos, en especial de los alimentos, cobra cada día más importancia, para lo que suelen usarse todo tipo de...